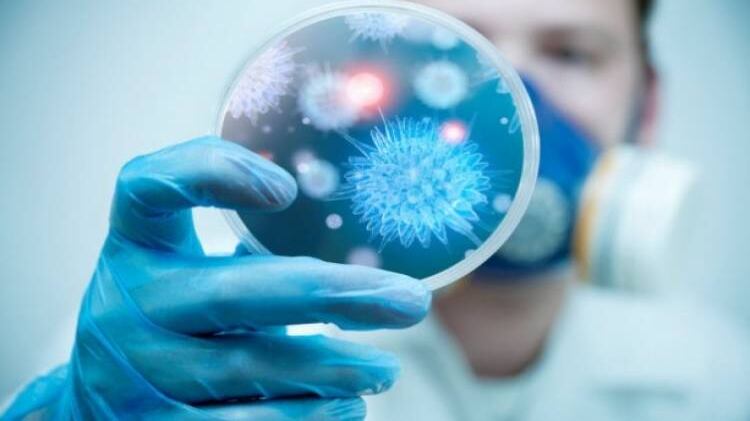
تسجيل إصابة سادسة لفيروس كورونا

خاص-أثير
أكد معالي الدكتور أحمد السعيدي وزير الصحة بأن السلطنة دائما ما تتخذ الوسطية والاعتدال في الإجراءات للتعامل مع الحالات المرضية، مشيرًا إلى أن إيقاف الرحلات الدولية أو ما يتعلق بالتبادل التجاري تعتمده السلطنة وفق ما يتم الإعلان عنه من قبل منظمة الصحة العالمية.
وأكد معالي الدكتور بأن مبدأ الشفافية في القطاع الصحي مشهود به على مستوى السلطنة، مشيرًا إلى أن الحالة الصحية للمواطنتين المصابتين بفيروس كورونا لا تستدعي تنويمهما في المستشفى في الوقت الحالي.
وقال معاليه أثناء استضافته في تلفزيون سلطنة عمان : رصد هاتين الحالتين هو دليل على مدى متانة ودقة الترصد الوبائي في السلطنة، وأريد أن أطمئن المواطنين بأن المختبر المركزي في السلطنة هو مختبر معتمد من قِبل منظمة الصحة العالمية كمختبر مرجعي لإقليم شرق المتوسط، لذلك السلطنة مرت كبقية دول العالم بفاشيات سابقة تعلمنا منها الكثير، واستعداداتنا بدأت منذ أول لحظة أُعلن فيها عن الفيروس في جمهورية الصين الشعبية، وتدريب المعنيين في القطاع الصحي والتعاون مع المؤسسات الحكومية والأهلية الأخرى، على سبيل المثال لا الحصر، مع المطارات وشرطة عمان السلطانية فيما يخص المنافذ الحدودية.
كما أكد معاليه بأنه لا داعٍ للفحص عن الفيروس إلا حسب الإجراءات الطبية، مشيرًا إلى أن هناك معايير وأسسا علمية متى يتم الفحص، مضيفا: لذلك أحب أن أطمئن المواطنين بأن القطاع الصحي في السلطنة سواءً الحكومي أو الخاص على دراية بما يجب عمله وأرجو منهم اتباع الإرشادات.